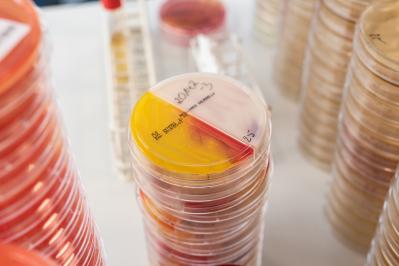

Analysis of Baby Food
The term baby food covers a number of different foods for infants and young children. These include infant formula, follow-on formula, processed cereal-based foods and other complementary foods. During the first months of an infant's life, breast milk is usually fed. If this is not the case, breast milk substitutes are prepared. After that - from about the fifth month, the diet is changed to follow-on formula and can be supplemented with complementary foods.
Infant formula and follow-on formula are subject to strict legislation and may only be placed on the market under the conditions set out in Delegated Regulation (EU) No. 2016/127. Infants and young children belong to a sensitive consumer group that requires special protection, so controls and laws regarding food composition, microbiological safety, and limits on residues and contaminants are particularly high. For example, the limits for pesticides in baby food are lower than in other foods because the exposure is much higher when the body weight is so low. In addition, it is of particular importance to maintain the nutrient and vitamin levels specified in dietary regulations to allow babies to grow healthily.
Due to the lower limits, extremely sensitive methods and state-of-the-art equipment are required for analysis. The accredited laboratories of the Tentamus Group have both, as well as the necessary expertise to evaluate the results and provide competent advice.
Challenges for producers & distributors of baby food
The regulation on dietetic foods precisely specifies the necessary vitamins, minerals and nutrients that a baby needs for healthy growth. Too high or too low content can lead to health consequences. This means that manufacturers of baby food must comply with these special requirements and have their products precisely analyzed. The reference values for the various foods for infants and young children are listed in detail in the dietary regulations in the appendix. This often very low concentration requires precise analysis with sensitive equipment.
All claims on the packaging regarding vitamins, nutrients and minerals must be confirmed by an accredited laboratory. If, for example, a certain amount of vitamin A, vitamin C and biotin is stated on the packaging, this must also be verified.

Necessary tests for the analysis of baby food
Tentamus Group laboratories offer the complete spectrum of analysis for baby food and its raw materials. We have the most modern laboratory equipment as well as the necessary know-how. Our experts regularly undergo further training and are therefore always up to date with the latest regulations and laws.
Residues & Contaminants
The analysis of residues and contaminants is of great importance, as these have significantly lower legal limits for baby food than other foods. Particularly relevant are:
- 3-MCPD & glycidyl esters / free MCPD & glycidol.
- Chlorate/Perchlorate
- Chlormequat & Mepiquat
- Dioxins & PCBs (dioxin-like & non-dioxin-like PCBs)
- Preservatives
- Mineral oil residues
- Mycotoxins
- Nitrates & Nitrites
- Pesticides
- Polycyclic aromatic hydrocarbons (PAH)
- Pyrrolizidine alkaloids (28 substances)
- Quaternary ammonium compounds (QAV)
- Heavy metals such as lead & copper
- Veterinary drug residues
- Tropane alkaloids
- Plasticizers (phthalates)
These contaminants can enter the products through the raw materials, storage conditions and processing steps, where they are subject to strict maximum levels that must not be exceeded.
Residues and contaminants are analyzed by means of LC-MS/MS, LC-GC, HPLC, GC-MS, LC-MS, GC-MS/MS, among others
Microbiological Contamination
Microbiological analysis of baby and infant food for hygiene and indicator germs, pathogenic germs & their toxins as well as spoilage agents. Germs such as Salmonella can cause severe illness in babies, as they react more severely to fluid loss through diarrhea than adults.
For most microbiological testing, samples are applied to specific culture plates and incubated. Bacterial colonies are counted and evaluated after incubation. Other common methods include ELISA testing and PCR testing.
Molecular biological analysis
Molecular biological relevant analyses of baby food are GMO screening and allergen analysis. Comprehensive allergen analysis is important, for example, for hypoallergenic baby food, but also for safe allergen management. This provides you with a secure basis with regard to trace labels and uncovers unintentional allergen inputs.
Sample shipment
of baby food
For the analysis of your baby food you have several possibilities to send the samples to our laboratories:
- You can bring your samples in person during our opening hours or send them to us.
- You can order a sample collection from us.

Relevant legal bases & directives
- Commission Directive 2006/141/EC (infant formulae and follow-on formulae)
- Commission Directive 2006/125/EC (processed cereal-based foods and baby foods for infants and young children)
- Regulation (EC) No 396/2005 of the European Parliament and of the Council (maximum levels of pesticide residues)
- Commission Regulation (EU) No 2023/915 (contaminants)
- Commission Regulation (EC) No 2073/2005 (consolidated text) (microbiological criteria for food)
- Regulation (EU) No. 609/2013 of the European Parliament and of the Council
- Dietary Regulation
Get in touch with our team:
food@tentamus.com
+49 30 206 038 230
Overview of
laboratories offering analysis of baby food
The following laboratories from the Tentamus Group offer the analysis of baby food:
This could also be of interest to you: